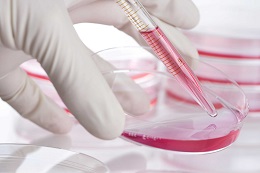

12 December 2018
Twelve UniSA researchers have collectively been awarded almost $12 million from the National Health and Medical Research Council (NHMRC) for projects in 2019 which tackle Australia’s most serious health challenges.
Twelve UniSA researchers have collectively been awarded almost $12 million from the National Health and Medical Research Council (NHMRC) for projects in 2019 which tackle Australia’s most serious health challenges.
Among the successful applicants is Professor Alex Brown, who will use a $2.5 million grant to develop and deliver a model of culturally-appropriate health and social services to Aboriginal and Torres Strait Islander people in order to improve social and emotional wellbeing and chronic disease outcomes.
Professor Brown, a Deputy Director of the South Australian Health and Medical Research Institute (SAHMRI) and global leader in Aboriginal health, says “the award is recognition of the critical role that social factors play in driving disparate health outcomes for Aboriginal individuals, families and communities. Only if we can adequately deal with some of the root causes of chronic conditions like diabetes, can we hope to see meaningful improvements in the lives of our people.”
Funding has also been awarded for continuing research into cancer, dementia, obesity, kidney disease and melanoma.
UniSA’s other successful applicants for the 2019 project grants include:
- Professor Sharad Kumar: $751,653 to investigate the impact of dietary salt on kidney disease severity and how a lack of a specific protein called Nedd4-2 leads to kidney disease; and $422,127 to better understand how cancer cells survive and can be targeted;
- Dr Tasha Stanton: $1.19 million to pilot a new pain-relieving treatment for people with knee osteoarthritis;
- Associate Professor Nicole Pratt: $1.16 million to investigate the use and safety of biologic medicines (immune-based drugs made inside living cells) and their potential side effects;
- Dr Christopher Hahn: $1.3 million to use new DNA sequencing techniques to screen families with genetic mutations and explore their role in blood cancers such as leukaemia and lymphoma;
- Associate Professor Claudine Bonder: $805,249 to help control the spread of melanoma cells in the body and provide new options to combat skin cancer;
- Dr Philip Gregory: $782,078 to explore the role of an RNA splicing protein called QKI-5 in driving the spread of prostate cancer;
- Associate Professor Carol Maher: $737,127 to tackle Australia’s obesity crisis, tracking obese adults over 12 months to find out high-risk times for weight gain and the impact of diet, lifestyle, exercise, culture and sleeping patterns on weight;
- Associate Professor Paul Anderson: $681,653 to develop a drug that prevents Vitamin D degradation and use it to treat bone disorders associated with chronic kidney disease;
- Professor Elina Hypponen: $447,599 to identify metabolic pathways which lead to dementia and to develop new prevention strategies and drugs to target the disease;
- Professor Benjamin Thierry: $432,192 to use immuno-PET imaging to detect metastatic deposits in regional lymph nodes in head and neck cancer, sparing patients unnecessary surgery and improving treatment.
UniSA’s success rate for NHMRC project applications this year was 21.67 per cent, compared to a national average of 17.29 per cent, a result applauded by UniSA Vice-Chancellor David Lloyd.
“These projects demonstrate the breadth and depth of research at UniSA in areas that have been identified as the most crucial health issues facing Australia,” Prof Lloyd says.
“Winning NHMRC grants is incredibly competitive and requires world-class research with the best chances of success, focusing on the most pressing health challenges in society. It is an extremely good result for our researchers and we are proud of their achievements.”
Media contact: Candy Gibson mobile 0434 605 142 email mailto:candy.gibson@unisa.edu.au




